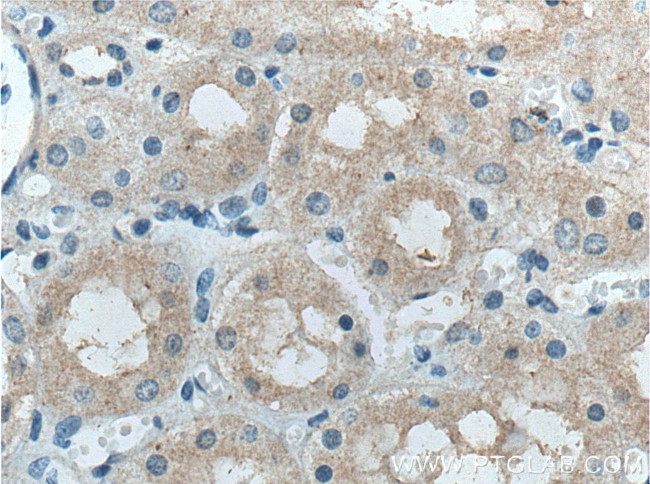
FBXO27 Antibody in Immunohistochemistry (Paraffin) (IHC (P))

Search
Proteintech
FBXO27 Polyclonal Antibody
{{$productOrderCtrl.translations['antibody.pdp.commerceCard.promotion.promotions']}}
{{$productOrderCtrl.translations['antibody.pdp.commerceCard.promotion.viewpromo']}}
{{$productOrderCtrl.translations['antibody.pdp.commerceCard.promotion.promocode']}}: {{promo.promoCode}} {{promo.promoTitle}} {{promo.promoDescription}}. {{$productOrderCtrl.translations['antibody.pdp.commerceCard.promotion.learnmore']}}
产品信息
14570-1-AP
种属反应
已发表种属
宿主/亚型
分类
类型
抗原
偶联物
形式
浓度
规格
纯化类型
保存液
内含物
保存条件
运输条件
产品详细信息
Immunogen sequence: MGASVSRGR AARVPAPEPE PEEALDLSQL PPELLLVVLS HVPPRTLLGR CRQVCRGWRA LVDGQALWLL ILARDHGATG RALLHLARSC QSPARNARPC PLGRFCARRP IGRNLIRNPC GQEGLRKWMV QHGGDGWVVE ENRTTVPGAP SQTCFVTSFS WCCKKQVLDL EEEGLWPELL DSGRIEICVS DWWGARHDSG CMYRLLVQLL DANQTVLDKF SAVPDPIPQW NNNACLHVTH VFSNIKMGVR FVSFEHRGQD TQFWAGHYGA RVTNSSVIVR VRLS (1-283 aa encoded by BC030060)
靶标信息
F-box proteins, a critical component of the evolutionary conserved ubiquitin-protein ligase complex SCF (Skp1/Cdc53-Cullin1/F-box), recruit substrates for ubiquitination and consequent degradation through their specific protein-protein interaction domains. Novel human F-box proteins named FBG1, FBG2, FBG3, FBG4 and FBG5 constitute a third subfamily of mammalian F-box proteins. FBG genes are expressed in a limited number of human tissues including kidney, liver, brain and muscle tissues.
仅用于科研。不用于诊断过程。未经明确授权不得转售。
生物信息学
蛋白别名: epididymis secretory sperm binding protein; F Box Gama 5; F-box only protein 27; F-box protein FBG5; F-box/G-domain protein 5; FBG5
基因别名: FBG5; FBX27; FBXO27
UniProt ID: (Human) Q8NI29
Entrez Gene ID: (Human) 126433